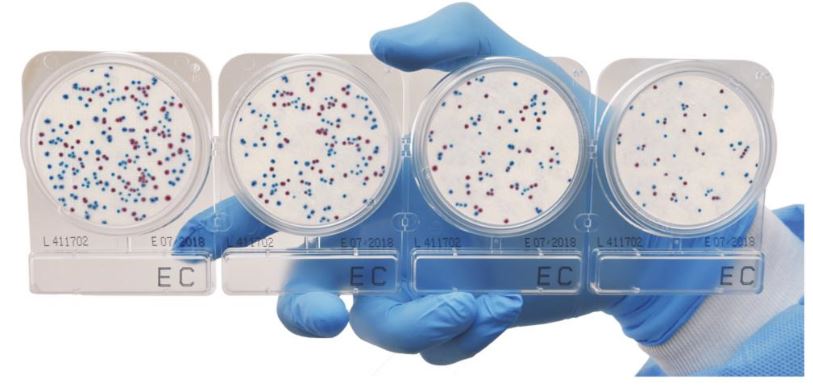

Compact Dry - Đĩa môi trường thạch đổ sẵn phân tích vi sinh nhanh chóng | Nissui
22/07/2019 | Tin công ty
Dân số thế giới đang tăng liên tục, và nhu cầu về các sản phẩm chất lượng và an toàn cũng vậy, mọi người tiêu thụ thực phẩm để sinh tồn, bổ sung chế độ ăn uống, và áp dụng mỹ phẩm để tự cải thiện bản thân. Nói chung, thực phẩm đang có sẵn trên thị trường dưới dạng đông lạnh, ướp lạnh, nấu chín và chế biến, trong khi dược phẩm và mỹ phẩm sẵn sàng để tiêu thụ và sẵn sàng để áp dụng. Vấn đề chung cho tất cả các sản phẩm này là cần phải được xử lý đúng như thành phẩm.
Chế biến thực phẩm, thực phẩm bổ sung, phụ gia và mỹ phẩm phù hợp phải phù hợp với các tiêu chuẩn do chính phủ hoặc bất kỳ tổ chức nào công nhận liên quan đến các sản phẩm nói trên. Để có thể đạt được điều này, các nhà sản xuất nên bắt đầu đầu tư vào các phương pháp kiểm tra an toàn thực phẩm khác nhau để đảm bảo chất lượng và an toàn cho sản phẩm của họ. Một trong những điều quan trọng nhất là đưa các sản phẩm vào phân tích vi sinh vật để xác minh xem những sản phẩm này có nằm trong tiêu chuẩn quy định của các ban quản lý an toàn sản phẩm cụ thể hay không. Cách làm xét nghiệm truyền thống là thông qua phương pháp đổ đĩa thạch truyền thống, có thể mất khoảng hai đến bảy ngày tùy thuộc vào vi sinh vật cần quan tâm. Thêm vào đó là các phương pháp xác định, đặc biệt đối với các mầm bệnh, cần xác nhận thêm như xét nghiệm sinh hóa hoặc thậm chí xét nghiệm nhận dạng phân tử. Với các phương pháp truyền thống này, thực phẩm chế biến không thể dễ dàng được tuyên bố là tốt để cung cấp hoặc thông qua kiểm soát chất lượng. điều này dẫn đến doanh thu chậm hơn, chi phí lưu kho bổ sung và hàng tồn kho với thời gian sử dụng ngắn hơn.
Để giải quyết vấn đề này, các nhà sản xuất chuyển sang các công cụ thay thế có thể thực hiện chức năng tương tự nhưng cho kết quả nhanh hơn mà không làm mất đi độ nhạy và độ đặc hiệu. Một công cụ như vậy là Compact Dry, một sản phẩm của công ty dược phẩm Nissui có trụ sở tại Nhật Bản, một sự đổi mới của phương pháp đổ đĩa thông thường và tương lai của ngành kiểm nghiệm vi sinh. Compact Dry là đĩa môi trường được đổ sẵn, tạo màu sẵn sàng để sử dụng thay thế trực tiếp cho phương pháp thông thường. Compact Dry loại bỏ công việc nặng nhọc của việc chuẩn bị và khử trùng theo phương pháp truyền thông. Trong các công ty sản xuất lớn, tổng cộng bốn đến sáu giờ mỗi ngày có thể được lưu trong xét nghiệm vi khuẩn tổng thể, có thể được sử dụng cho các bài test trong phòng thí nghiệm khác. Hơn nữa, đối với các công ty siêu nhỏ, nhỏ và vừa có cơ sở vật chất hạn chế, việc sử dụng hoặc bộ kiểm tra nhanh cũng là một lợi thế vì nó chỉ cần một không gian nhỏ, không cần đầu từ nhiều máy móc thiết bị mới có thể thực hiện.
Để giải quyết vấn đề này, các nhà sản xuất chuyển sang các công cụ thay thế có thể thực hiện chức năng tương tự nhưng cho kết quả nhanh hơn mà không làm mất đi độ nhạy và độ đặc hiệu. Một công cụ như vậy là Compact Dry, một sản phẩm của công ty dược phẩm Nissui có trụ sở tại Nhật Bản, một sự đổi mới của phương pháp đổ đĩa thông thường và tương lai của ngành kiểm nghiệm vi sinh. Compact Dry là đĩa môi trường được đổ sẵn, tạo màu sẵn sàng để sử dụng thay thế trực tiếp cho phương pháp thông thường. Compact Dry loại bỏ công việc nặng nhọc của việc chuẩn bị và khử trùng theo phương pháp truyền thông. Trong các công ty sản xuất lớn, tổng cộng bốn đến sáu giờ mỗi ngày có thể được lưu trong xét nghiệm vi khuẩn tổng thể, có thể được sử dụng cho các bài test trong phòng thí nghiệm khác. Hơn nữa, đối với các công ty siêu nhỏ, nhỏ và vừa có cơ sở vật chất hạn chế, việc sử dụng hoặc bộ kiểm tra nhanh cũng là một lợi thế vì nó chỉ cần một không gian nhỏ, không cần đầu từ nhiều máy móc thiết bị mới có thể thực hiện.
Compact Dy rất dễ sử dụng và không yêu cầu đào tạo bài bản mới có thể thực hiện. Bộ kiểm tra nhanh này có sẵn trong 15 thông số bao gồm các sinh vật hư hỏng, mầm bệnh và các thông số đặc biệt khác. Cùng với các công nghệ tương tự khác, Compact Dry là giải pháp mới duy nhất có các xét nghiệm khả dụng đối với Enterococcus, Vibrio Parahaemolyticus, Pseudomonas aeruginosa và tổng số lượng trong Trà. Nó cũng cung cấp giảm thời gian thử nghiệm cho ecoli coliform, và nấm men và nấm mốc chỉ với 24-72 giờ thời gian ủ, tương ứng, một phát triển sản phẩm khác là một phần của tập đoàn Nissui cam kết đổi mới liên tục và cung cấp các giải pháp tốt nhất cho thử nghiệm vi khuẩn khác nhau yêu cầu.
Công ty TNHH AZ LAB hiện đang là nhà phân phối chính thức đĩa môi trường đổ sẵn Compact Dry của hãng Nissui tại Việt Nam. AZ LAB cung cấp đa dạng tất cả các chỉ tiêu cần kiểm nghiệm trong ngành thực phẩm, trong môi trường và một số ngành khác.
Quý khách hàng có thể tham khảo thêm thông tin sản phẩm tại:
http://azlab.vn/vi/shops/dia-compact-dry/dia-kiem-tra-vi-khuan-nhanh-compact-dry-nissui.html
Nguồn tin: azlab.vn
Tin tức khác?
Que lấy mẫu vi sinh bề mặt ESC Liofilchem
ESC (Easy Surface Checking ) swab bao gồm nhiều dạng lấy mẫu cho vi sinh , kiểm...
QUE TEST NHANH VI SINH HAI MẶT CONTACT SLIDE
Que hai mặt kiểm tra vi sinh Contact slide - Giải pháp ưu việt trong kiểm soát...
Argentina đã phát triển phương pháp mới phát hiện histamin trong thủy sản
Viện Công nghệ Công nghiệp Quốc gia Argentina (INTI) đã đưa ra một phương pháp...
Quy định về hàm lượng Histamine trong thủy sản theo phương pháp HPLC
Ngày 23/10/2013, Hội đồng Châu Âu ban hành Quy định (EU) số 1019/2013 về việc...






